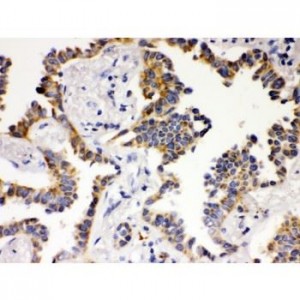
ATG14L  Antibody

Immunohistochemistry (IHC)
Showing 973–984 of 1068 resultsSorted by latest
-

ATP2A3 Antibody
$330.00 Add to cart -

ATP2A2 Antibody
$330.00 Add to cart -

ATP2A1 Antibody
$330.00 Add to cart -
ATG14L Antibody
$365.00 Add to cart -

ATF2 Antibody
$365.00 Add to cart -

ATF1 Antibody
$365.00 Add to cart -

Ataxin 3 Antibody
$330.00 Add to cart -

Ataxin 3 Antibody
$365.00 Add to cart -

Ataxin 1 Antibody
$365.00 Add to cart -

ASPH Antibody
$365.00 Add to cart -

Aryl hydrocarbon Receptor Antibody
$330.00 Add to cart -

ARSA Antibody
$365.00 Add to cart